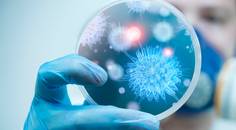
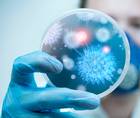

advertisement
Diabetes and Endocrinology
33-48 of 224
- Medical NewsNew Therapy Combines Procedure with Semaglutide to Potentially End Insulin Use in Type 2 Diabetes
medicalxpress.com
10/22/2024
sciencedaily.com
10/21/2024
eurekalert.org
10/21/2024- Medical News‘Sweat, Spike, Solve’: Research Suggests a New Strategy for People with Type 1 Diabetes to Lower Blood Sugar After Exercise
ualberta.ca
10/14/2024 - Medical NewsStudy Shows Adolescence and Young Adulthood Are Risky Periods for Those Living with Diabetes
medicalxpress.com
10/09/2024
medicalxpress.com
10/07/2024
news.liverpool.ac.uk
10/07/2024- Medical NewsUnderstanding Glucose Levels in Non-Diabetics: New Findings from Continuous Glucose Monitoring
medicalxpress.com
10/02/2024
medicalxpress.com
10/02/2024- Medical NewsStudy Suggests Semaglutide May Help Reduce Hidradenitis Suppurativa Symptoms in Obese Patients
news-medical.net
10/01/2024
eurekalert.org
09/30/2024
newswise.com
09/27/2024- Medical NewsCleveland Clinic Study Shows Bariatric Surgery Outperforms GLP-1 Diabetes Drugs for Kidney Protection
newsroom.clevelandclinic.org
09/25/2024 - Medical NewsMount Sinai Study Identifies Link Between Prediabetes During Adolescence and Young Adulthood with the Likelihood of Adverse Pregnancy Outcomes
mountsinai.org
09/24/2024
medicalxpress.com
09/24/2024
cardiff.ac.uk
09/24/2024